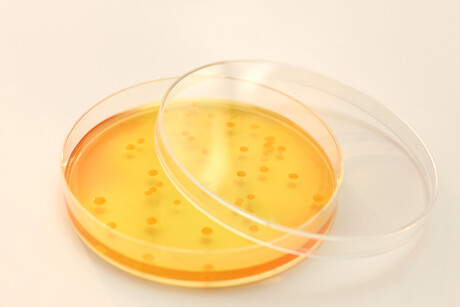
Golden staph&#39;s antibiotic resistance genes uncovered

Golden staph's antibiotic resistance genes uncovered
Australian researchers led by The Peter Doherty Institute for Infection and Immunity have uncovered new genetic insights into Staphylococcus aureus, revealing what makes the bacterium so dangerous when it enters the blood.
While common, S. aureus infections — known as golden staph — can be life-threatening if the bacteria enter the bloodstream, causing sepsis. Golden staph is notorious for its ability to become resistant to antibiotics, making it hard to treat, which can lead to adverse health outcomes for patients infected with a drug-resistant form of the bacteria.
In one of the most comprehensive studies of its kind, the research team analysed the unique genetic profiles of more than 1300 golden staph strains. By combining this data with patient and antibiotic information, the researchers found that, while patient factors are critical in determining mortality risks, specific genes are linked to antibiotic resistance, along with the bacteria’s ability to linger in the blood, evading antibiotics and the immune system.
Dr Stefano Giulieri, a clinician-researcher at the Doherty Institute and first author of the study, said the findings — published in the journal Cell Reports — highlight the diagnostic power of integrating clinical and genomic data.
“To the best of our knowledge, this is one of the first times that the method we used, called a genome-wide association study (GWAS), has been applied to delve into the role of bacterial genomes, host factors and antibiotics on the course of staphylococcal sepsis,” Giulieri said.
“In GWAS, scientists scan the genome of a big collection of bacteria to look for tiny changes (mutations) that show up more often in strains with a certain characteristic, such as antibiotic resistance. Mutations with a strong statistical link are precious clues to figure out how bacteria acquire attributes that are important for patient outcomes.
“Our study uncovered a deeper understanding of the intricate genetic dynamics underlying severe golden staph infections. It highlights the potential of combining bacterial whole-genome sequencing, clinical data and sophisticated statistical genomics to discover clinically relevant bacterial factors that influence infection outcomes.”
Co-senior author Professor Ben Howden, Director of the Microbiological Diagnostic Unit Public Health Laboratory at the Doherty Institute, said that this work represents a significant advancement in medical research as it reshapes our strategies against complex health challenges like golden staph infections.
“By revealing the genes responsible for antibiotic resistance in golden staph, our GWAS is pointing the scientific community to clearer targets for the development of effective solutions to treat golden staph bloodstream infections,” Howden said.
“This knowledge has the potential to shape and enhance our ability to tackle these persistent infections. As bacterial genomes become increasingly available in the clinical routine, we inch closer to customised therapeutic strategies, where treatments will be tailored to the unique genetic makeup of the infecting strain, rather that treating everyone in the same way.”
Australia's first cases of H5 avian influenza confirmed
Positive results for H5 avian influenza (bird flu) have been confirmed in two seabirds found in...
AusBiotech partners with Tenmile
Designed to support Australia's homegrown life sciences innovation, AusBiotech has announced...
Australian CDC issues update in wake of Ebola outbreak
After the WHO determined the outbreak of Ebola in the DRC and Uganda to be a public health...



